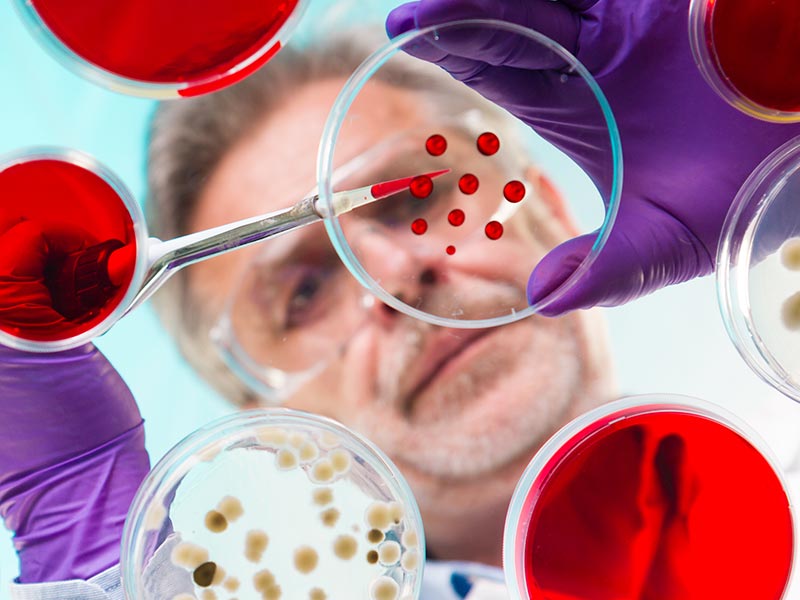

Keitä me olemme
Turun Mikrobiologien Tiedesäätiö/Åbo Mikrobiologiska Vetenskapsstiftelse perustettiin vuonna 1992 edistämään infektiotautien, autoimmuunisairauksien ja ihmisen immuunipuolustusjärjestelmän tieteellistä tutkimusta.

Tiedesäätiö
Turun Mikrobiologien Tiedesäätiön tehtävä on tukea taloudellisesti mikrobien aiheuttamien infektiotautien tutkimusta, mikrobiston epätasapainotilojen ja auto- immuunisairauksien tutkimusta, sekä työtä, joka tähtää immuunijärjestelmän syövältä suojaavan toiminnan ymmärtämiseen ja tehostamiseen.
Tiedeseura
Turun Mikrobiologien Tiedeseura perustettiin vuonna 1985 edistämään lääketieteellisen mikrobiologian alaan kuuluvaa tieteellistä tutkimusta. Tiedeseura järjestää tapahtumia ja ekskursioita, joissa mikrobiologian ja immunologian parissa työskentelevät ja alaa opiskelevat verkostoituvat ja saavat uusia ideoita.

Lahjoitusohjeet
Yhteiskunnan tuki tutkimustoimintaan on enenevästi riittämätöntä, jolloin säätiöiden rooli tutkimuksen rahoituksessa kasvaa. Halutessasi tukea säätiön toimintaa, ole meihin yhteydessä. Myös merkkipäivämuistamiset voi ohjata tukemaan säätiön toimintaa. Säätiö ottaa vastaan myös testamenttilahjoituksia.

Tiedesäätiön matka-apurahoilla verkostoitumaan maailmalle
Turun Mikrobiologien Tiedesäätiö myöntää vuosittain matka-apurahoja, jotka Turun Mikrobiologien Tiedeseura jakaa jäsenilleen. Matka-apurahojen turvin seuran jäsenet voivat osallistua tieteellisiin kokouksiin, saavat näkyvyyttä tutkimustuloksilleen ja voivat luoda yhteyksiä muihin tutkijoihin.
Vuonna 2025 apurahoja myönnettiin yhteensä 12 500 €. Apurahoilla rahoitettiin mm. matkoja konferensseihin, kuten EMBO EMBL Symposium The Human Microbiome (Saksa, Heidelberg) ja European Society of Clinical Microbiology and Infectious Diseases 2025 (Itävalta, Wien), tutkimusvierailu Japaniin Tokion yliopistoon sekä tuettiin tieteellisen kokouksen järjestämistä täällä Suomen Turussa.
